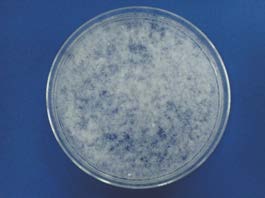
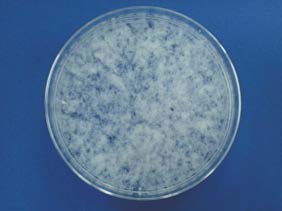

WSP事業
FAQ
よくあるご質問

FAQ
WSP事業についてのよくあるご質問
- CMCの一般品と耐酸,耐塩品との違いは?
一般品はエーテル化度が0.7程度、耐酸,耐塩品はエーテル化度が0.8以上のCMCを指します。
一般品は、水溶液に塩が入ったり、pHが低くなった場合、水溶液が白濁して粘度が極端に下がる場合があります。
これはCMCが不溶化して析出してしまうためですが、エーテル化度が高いCMCは、この現象が発生せずに粘度を維持できます。
- 水溶液にした時に溶けていないものは何? どのように溶かす?
CMCやHECは、セルロースを不均一系でエーテル化反応させているため、製品中に反応しなかったり、反応が十分に進まなかった セルロースがわずかに存在します。
この未反応ファイバーや、溶けきれずに膨潤している未溶解ゲルは、時間をかけても温度を上げても溶解しません。
乾燥時に熱架橋した未溶解ゲルは、pHを上げてアルカリ状態にすると溶解する場合があります。
- DS(エーテル化度)やMS(モル置換度)とは? HECのDSとMSは、どれくらい?
DSは、セルロースの1つのグルコースに存在する3つの水酸基が平均どの程度エーテル化剤で置換されているかを表します。理論上の最大DSは3.0です。
HECの場合、セルロースの水酸基は酸化エチレンで置換されますが、セルロースの1つのグルコース当たりの酸化エチレンの平均付加モル数を表します。HECダイセルのDSは、1.3程度、MSは2.2程度です。
- CMCはどのように水に溶解させたらいい?
CMCは粒子の溶解が極めて早いため、水に触れると粒子同士が集合粘着し、”ママコ”を形成します。
ママコが形成されると溶解に非常に時間がかかります。溶解がうまくいかない場合、下記のような方法を試してみてください。- 激しく水面付近を攪拌しながら、できるだけ少量づつ粉体を落とす
目の粗い篩いを通しながら投入しても効果あり - 水に不溶な粉体原料と事前に混合してから水に投入する
- 水と相溶する溶媒(エタノールなど)にCMCを分散させた上で、水に投入する
- 激しく水面付近を攪拌しながら、できるだけ少量づつ粉体を落とす
- 製品の保管方法は?
直射日光を避け、温度・湿度の変化が少ない場所に保管し、開封後はできるだけ速やかに使い切って下さい。
- 長期保管によってどのような経時変化が起こりえる?
CMCやHECはセルロースを主原料とした水溶性高分子です。
吸湿性がありますので製品中の水分が増加したり、セルロースの解重合によって粘度が低下する恐れがありますので、必ず品質保証期間内にご使用下さい。また、セリッシュはセルロースを原料とし、多くの水分を含む製品ですので、開封後に使い切らず放置するとカビや微生物が発生する可能性があります。
- セリッシュの使用方法は?
セリッシュの微小繊維の特徴を生かすために、予め適量の水でよく分散して下さい。
セリッシュの分散にあたっては、ホモディスパーやジューサーミキサーを用い、目視にて「ツブ」の有無を確認して下さい。
「ツブ」がほとんど無くなった状態がセリッシュの『完全分散』です。- 1. 開封時

- 2. 手分散

- 3. 分散不十分

- 4. 分散OK
- 5. 完全分散
- 1. 開封時
- CMCダイセルを食品に用いるときの表示は?
食品として使用する場合、以下の通り表記してください。
CMCダイセル セリッシュ 表示 カルボキシメチルセルロースナトリウム 微小繊維状セルロース 簡略名 CMC
CMC-Na
繊維素グリコール酸ナトリウム
繊維素グリコール酸Naセルロース 注記 1) 増粘剤,安定剤,ゲル化剤,糊料として使用する場合、用途を併記する必要あり
2) 多糖類を2種類以上併用する場合、増粘多糖類と表示できない1) 増粘剤,安定剤,ゲル化剤,糊料として使用する場合、用途を併記する必要あり
2) 多糖類を2種類以上併用する場合、増粘多糖類とも表示できる
- CMCダイセル、HECダイセルを化粧品、医薬部外品に用いるときの表示は?
化粧品として使用する場合、以下の通り表記してください。
[ 化粧品 ]
CMCダイセル HECダイセル 表示 セルロースガム ヒドロキシエチルセルロース 成分番号 551739 552078 定義 本品は、セルロースのカルボキシメチルエーテルのナトリウム塩である
参照表示名称:セルロース本品は、セルロースのヒドロキシエチルエーテルである
参照表示名称:セルロース配合目的 結合剤,乳化安定剤,皮膜形成剤,親水性増粘剤 結合剤,乳化安定剤,皮膜形成剤,親水性増粘剤 [ 医薬部外品 ]
CMCダイセル HECダイセル 添加物の名称 カルボキシメチルセルロースナトリウム ヒドロキシエチルセルロース 規格コード 51(医薬部外品原料規格2006) 51(医薬部外品原料規格2006) 成分コード 001202 102993 配合基準 薬用石鹸,シャンプー,リンス等,除毛剤,育毛剤,その他の薬用化粧品,腋臭防止剤・忌避剤,薬用口唇類,薬用はみがき類,浴用剤,染毛剤 パーマ剤 薬用石鹸,シャンプー,リンス等,除毛剤,育毛剤,その他の薬用化粧品,腋臭防止剤・忌避剤,薬用口唇類,薬用はみがき類,浴用剤,染毛剤 パーマ剤
- 通関に使用するHSコードは?
以下の通りです
CMCダイセル HECダイセル セリッシュ ティアラ HSコード 3912.31 3912.39 3912.90 3824.99
詳しくは、以下お問い合わせより
「CMC、HEC、ミクロフィブリル化繊維『セリッシュ®』」を選択し、ご相談ください。